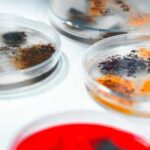

Nuclear Submarine Deal with South Korea
A new international partnership highlights President Trump's focus on strengthening alliances while protecting national interests.
Story Snapshot
The United States will share key technology with...
Dinosaurs Thrived Until Asteroid Impact
The mighty dinosaurs weren't gasping their last breath when that cosmic boulder slammed into Earth 66 million years ago—they were actually living their best...
Mammoths & Hippos: Unlikely Coexistence in Germany
Hippos wallowed in German rivers while woolly mammoths roamed the frozen landscape around them, defying everything scientists thought they knew about Ice Age Europe.
Story...
Mushrooms Powering Next-Gen Computers
Imagine a world where computers grow like plants, adapt like living organisms, and repair themselves. Welcome to the realm of fungal computing.
Story Snapshot
Mushroom...
Escalating Protests Redefine Democratic Rights
Escalating climate protests challenge free speech rights, prompting a global debate on protest legitimacy and state response.
Story Highlights
Increasingly disruptive climate protests test free...
Hyunmoo-5: A Strategic Defense Shift
South Korea's deployment of the "monster missile" Hyunmoo-5 marks a strategic shift away from decades of American military dependence toward indigenous defense capabilities.
Story Snapshot
...
Russia Oil Hit: Market Reacts
President Trump has unleashed sweeping sanctions targeting Russia's oil giants, sending global energy prices soaring.
Key Points
Trump imposed sanctions on Russia's two largest oil...
ChatGPT Privacy: A Legal Trap?
Your private conversations with ChatGPT can be subpoenaed and used as evidence against you in court, with zero legal protections—and OpenAI's own CEO is...
Ceasefire Fragile After IDF Strikes
Two Israeli soldiers have been killed, sparking a heated military response in Gaza that puts the fragile ceasefire to the test.
Story Highlights
Israeli strikes...
OJ 287: Merging Black Holes & Plasma Jets
Somewhere in the black heart of the universe, two monstrous black holes locked in a cosmic dance send a jet of plasma arcing through...